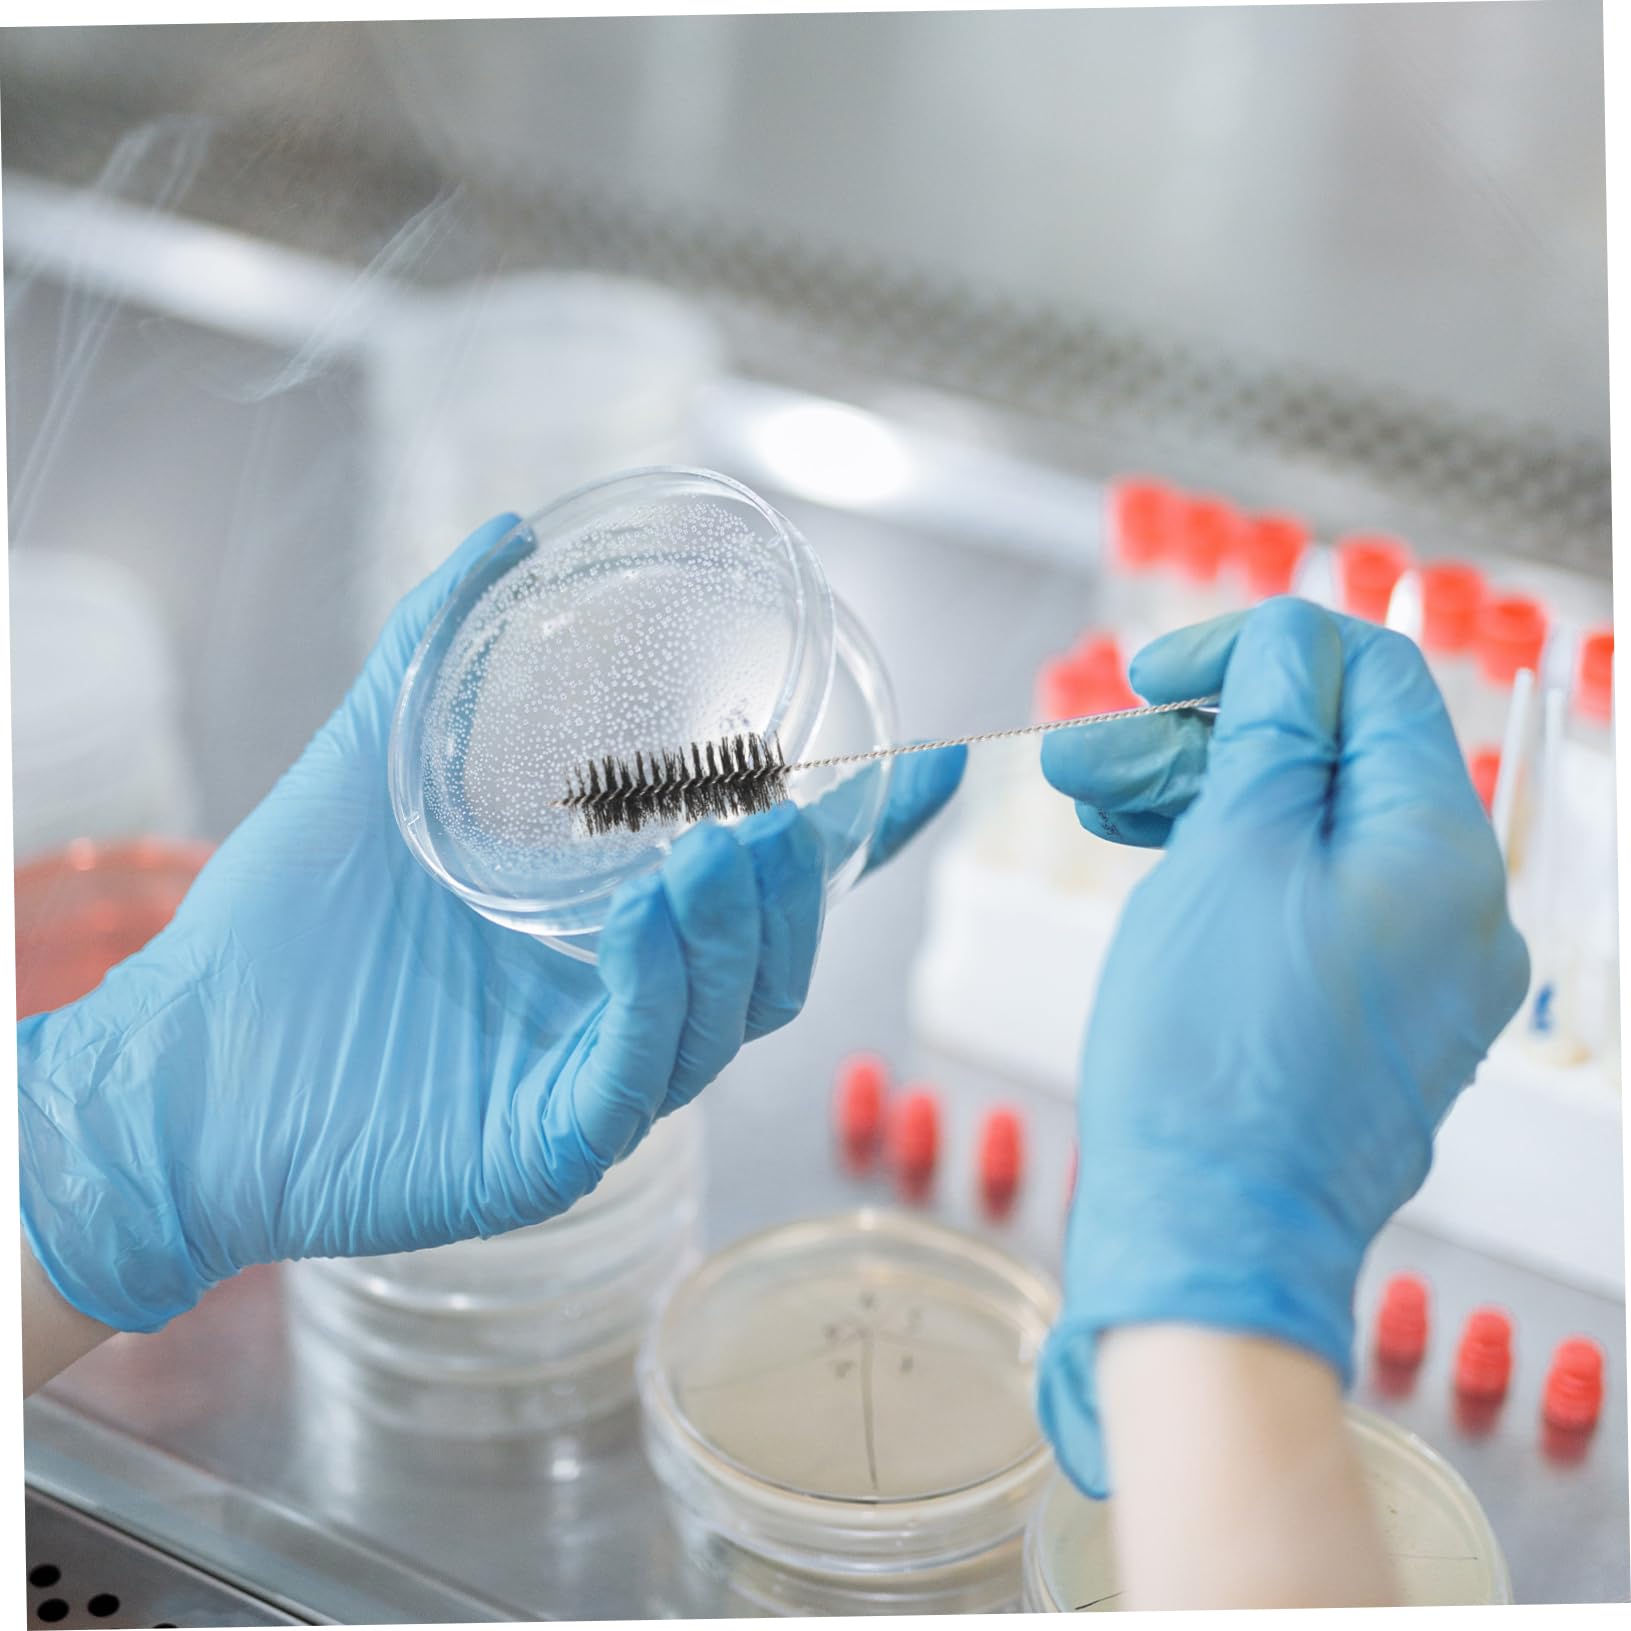
MUSISALY 5pcs Tattoo Equipment Cleaning Tools Bottle Scrub Brush Bottle Cleaner Brush Gel Test Tube Brushes for Cleaning Narrow Bottle Brush Scrubbing Tube Cleaning Brush Clear Kit Nylon

Product Information
Specification
Brand : MUSISALY
BulletPoint1 : Bottle cleaning:the stainless steel handle has certain flexibility, with a ring-shaped hook, which can be hung up conveniently,bottle cleaning brush
BulletPoint2 : Water bottle for cleaning:cleaning brush are a must-have tool for professional tattoo equipment cleaning and labs tube cleaning,water bottle cleaning brush
BulletPoint3 : Tube brush:these small bottle are manufactured with stainless steel and nylon bristle materials for durability and reliability,scrubbing brush
BulletPoint4 : Narrow bottle brush:the are widely used, can be used to clean the home, kitchen and chemical laboratory accessories cleaning,bottle cleaner
BulletPoint5 : Test tube for cleaning:tube are small and compact, light and convenient, designed for easy carrying,bottle cleaner brush
Color : As Shown
IncludedComponents : brush
ItemDisplayDimensions_Height : 0.39 inches
ItemDisplayDimensions_Length : 4.33 inches
ItemDisplayDimensions_Width : 1.77 inches
ItemName : MUSISALY 5pcs Tattoo Equipment Cleaning Tools Bottle Scrub Brush Bottle Cleaner Brush Gel Test Tube Brushes for Cleaning Narrow Bottle Brush Scrubbing Tube Cleaning Brush Clear Kit Nylon
ItemPackageDimensions_Height : 0.39 inches
ItemPackageDimensions_Length : 5.12 inches
ItemPackageDimensions_Width : 4.72 inches
ItemTypeKeyword : science-lab-tube-cleaning-brushes
Manufacturer : MUSISALY
Material : Iron
Material1 : Stainless Steel
Material2 : Nylon
ModelName : Other (Tattoo Supplies)
ModelNumber : 42C42L8UXP2FF8JWF116HAIF9
NumberOfLithiumMetalCells : 1
PartNumber : 42C42L8UXP2FF8JWF116HAIF9
ProductDescription : Package List
5 x Nylon Tube
Features
-Material:Stainless steel, nylon bottle cleaner brush
-Color:As Shown jewelry cleaning brush
-Size:11.00X3.00X0.50cm/4.32X1.18X0.20in bottle for cleaning
- Nylon tube , allowing hard-to-reach spaces cleaning, which allow you to clean the inside and bottom of tubes small bottle brush.
- The stainless steel handle has certain flexibility With a ring-shaped hook, which can be hung up conveniently tube cleaning brush.
- These small bottle are manufactured with stainless steel and nylon bristle materials for durability and reliability bottle cleaning.
- Nylon small cleaning are suitable for washing small bottles, test tube, tattoo tools, etc bottle brush.
- Clean your tattoo equipment with stainless steel test nylon tube Essential for maintaining tattoo equipment narrow bottle brush.
Goods Description
scrubbing brush The small bottle brush set is made of nylon and stainless steel, which is strong and sturdy, difficult for them to rust or break.bottle cleaning The quantity of small bottle brush is sufficient quantity and good combinations to cleaning your water and other tattoos equipment
ProductSiteLaunchDate : 2024-11-04T04:06:37.109Z
Size : 11.00X3.00X0.50CM
SupplierDeclaredDgHzRegulation : not_applicable
UnitCount : 1
UnspscCode : 47131600